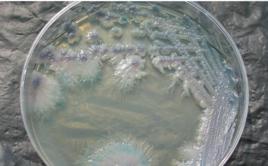
偽熱帶念珠菌 偽熱帶念珠菌

診斷
一、病史(一)好發於兒童、老年人、糖尿病患者、孕婦及月經期婦女;(二)口腔念珠菌病有不同程度的疼痛,吞咽困難及張口困難;(三)陰部念珠菌病瘙癢明顯,淺表性交痛;(四)皮膚念珠菌有不同程度的瘙癢;(五)系統性念珠菌若累及呼吸系統,常有發熱、咳嗽,痰粘難咳,累及消化系統可影響食慾,可有腹脹、腹痛及腹瀉等;累及泌尿系統常發熱,腰痛,尿濁及尿頻、尿急、尿痛等。
二、體徵(一)黏膜念珠菌病1.鵝口瘡:好發於舌部、軟齶、頰黏膜、牙齦及咽部,表現為口腔黏膜上附著一層灰白色的偽膜,去除偽膜則露出紅色糜爛面;嚴重者可發生潰瘍壞死;2.念珠菌性舌炎:舌面光滑、發紅、淺表潰瘍、有時可見黑毛舌;3.念珠菌性唇炎及口角炎:下唇中央糜爛或瀰漫性腫脹,口角浸漬發白,長期不愈者可見口角角化皸裂;4.念珠菌性角膜炎:角膜潰瘍、壞死、邊緣隆起呈反射狀浸潤,嚴重者會發生角膜穿孔;5.念珠菌性陰道炎:白帶多,呈凝乳狀、乳酪樣或豆腐渣樣,陰道壁充血水腫,有時可見黏膜上灰白色偽膜;6.念珠菌性龜頭炎:龜頭及冠狀溝潮紅、糜爛或乾燥多屑,或有丘疹及小膿皰。(二)皮膚念珠菌病1.念珠菌性間擦疹:好發於腋窩、乳房下、腹股溝、臀溝及指趾間;表現為紅斑、浸漬、糜爛,損害周圍可見鱗屑性丘疹、水皰或膿皰;2.念珠菌性甲溝炎及甲床炎:甲溝紅腫,滲液少,甲板增厚,出現溝紋,顏色變暗;3.念珠菌性丘疹病:好發於頸部、背部、肛周及陰部,表現為2~3mm大小暗紅色鱗屑性丘疹或丘皰疹;4.念珠菌性肉芽腫:好發於面部、口腔及肢端,表現為結節、潰瘍或肉芽腫,血管豐富,上附粘著的棕黃色厚痂,痂下可見凹凸不平的肉芽組織增生;5.慢性皮膚黏膜念珠菌病:幼年發病,病程緩慢,表現為口腔、皮膚、指甲及深部組織肉芽腫性損害。(三)系統性念珠菌病為念珠菌侵犯內臟器官所致,常見的有支氣管肺念珠菌病、消化道念球菌病及泌尿道念珠菌病等。若多個系統同時被念珠菌侵犯,則稱播散性念珠菌病,播散性念珠病病情重篤,預後不良。(四)念珠菌疹為念珠菌及其代謝產物引起的皮膚變態反應,主要損害為成群的無菌性水皰,多見於手指間;也可見到銀屑病樣、玫瑰糠疹樣、脂溢性皮炎樣、蕁麻疹樣、離心性環狀紅斑樣損害。
三、實驗室檢查(一)直接鏡檢,根據病變部位收集標本;如刮取鱗屑、偽膜、拭擦分泌物,留取痰、尿、糞、血、腦脊腋及活檢組織等,若鏡下見到成堆孢子有診斷價值,見到大量的假菌絲或真菌絲,則說明念珠菌處於致病狀態;(二)真菌培養:取標本接種於沙氏培養上,室溫培養24~48小時,可見奶油色酵母樣菌落生長;將菌落移至米粉瓊脂培養基上,若有芽孢及假菌絲則為念珠菌屬;若有頂端厚壁孢子,則為白念珠菌。發酵和同化試驗可進一步鑑定菌種。四、鑑別診斷黏膜念珠菌病需與黏膜白斑病,扁平苔蘚及陰道滴蟲病等鑑別;皮膚念珠菌病需與體股癬、皮膚結核及非感染性肉芽腫疾病鑑別;系統性念珠菌病需與結核病及腫瘤鑑別。
治療
一、治療原則(一)局限性皮膚黏膜念珠菌病宜採用局部療法;(二)頑固性、泛發性皮膚黏膜念珠菌及系統性念珠菌病宜採用系統療法;(三)調節患者的免疫功能,治療潛在性疾病。
二、治療方法(一)局部療法1.複方制黴菌素軟膏、洗劑或制黴菌素甘油(每ml或每克含制黴菌素1~2萬單位)外用,每日2~3次,連用1~2周;2.1%~3%克霉唑溶液或霜劑:外用,每日2次,連用1~2周;3.制黴菌素栓((5~10萬單位/栓):陰道內用藥,每晚1粒,連用1~2周;4.咪康唑栓劑(50mg/栓):陰道內用藥,每晚1粒,連用1~2周;5.1%聯苯苄唑霜或2%咪康唑霜:外用,每日2次,連用1~2周。(二)系統療法1.制黴菌素:每次100萬單位,每日3次,連服1周;2.酮康唑:每次0.2~0.4克,每日1次,連服1~2周;3.氟康唑:一般用藥,首日150~200mg,以後每日100mg,用藥至少2周;陰道念珠菌病150mg,頓服;播散性念珠菌病,每日400mg,以後每日200mg,療程視病情而定;4.伊曲康唑:一般用藥:每日200mg,飯後服,連服一周;陰道念珠菌病:每次200mg,每日2次,服用1天;播散性念珠菌病:每次0.2克,每日2次,連服1~3個月。5.二性黴素b:開始以每日每公斤體重0.05~0.lmg溶於5%葡萄糖溶液中靜滴,以後逐漸增量,最高量每日每公斤體重1mg;本品宜新鮮配製,避光使用。採用以上系統療法時,需定期檢查肝功能。